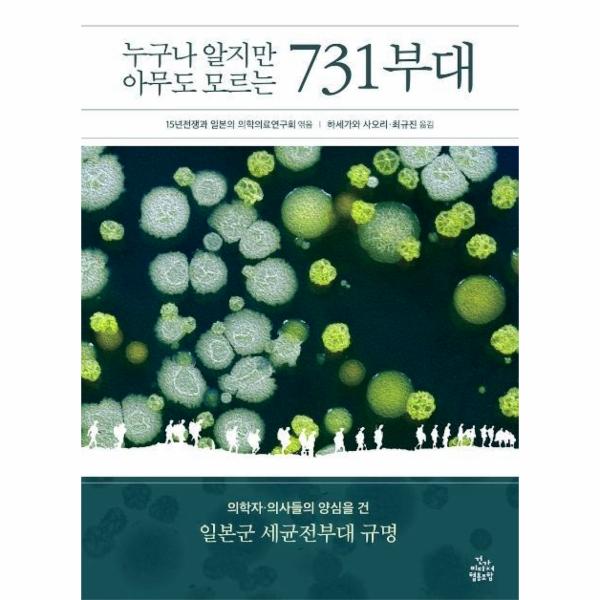

추천의 글 _ 황상익
들어가며 _ 니시야마 가쓰오(西山勝夫
1부 프롤로그
731부대를 어떻게 볼 것인가 _ 쓰네이시 게이이치(常石敬一
교토대 병리학교실사로 본 731부대의 배경 _ 스기야마 다케토시(杉山武敏
1. 오카모토 고조 선생님의 연구
2. 오카모토 고조 교수의 남다른 연구 정신
3. 하얼빈으로 가는 충격의 여정
4. 운명의 731부대 방문
5. 교토대학 병리학교실
6. 기요노 겐지 교수
7. 기요노 교수와 이시이 시로의 가가와현 뇌염 조사
8. 이시이 시로의 해외 시찰
9. 군의학교방역연구실 개설
10. 인체실험은 도고부대에서 시작
11. 관동군방역부
12. 이시이부대에 공헌한 군의들
13. 대학에서 이시이부대로 파견된 기사들
14. 기요노 사건에 의한 기요노 겐지의 실각
15. 기요노 겐지의 민족학과 우생사상
16. 실전에서의 세균무기에 대한 평가
17. 포로를 사용한 인체실험
나가며
2부 731부대의 소행
일본군 731부대에서 내가 겪은 경험들 _ 시노즈카 요시오(篠塚良雄
일본군 731부대 동상실험실 및 동상실험 _ 가리타 게이시로(刈田啓史?
1. 목적 및 자료
2. 자료 내용 및 고찰
2.1 동상실험실 구조
2.2 요시무라 히사토가 한 동상실험
3. 결론
A리포트와 G리포트(더그웨이문서 _ 아자미 쇼조(?昭三
1. 더그웨이문서
2. A리포트와 G리포트 등이 작성된 경위
3. A리포트(탄저균감염―실험 계획과 병리 변화 기록
3.1 A리포트의 대상과 실험 계획
3.2 각 증례 분석
3.3 장기별 병변 특징 기재
4. G리포트(비저균감염-실험 계획과 병리 변화 기록
4.1 G리포트 대상과 실험 계획
4.2 각 증례 분석
4.3 G리포트 병리 해부 소견에 관한 기술
5. A, G리포트의 현미경 표본 출처와 집필자
6. 고찰과 정리
6.1 『육군군의학교 방역연구보고』로 알 수 있는 전쟁 전 인체실험 사례
6.2 나치스 독일의
추천의 글
황상익 (서울대학교 의과대학 명예교수, 의학사
황상익 (서울대학교 의과대학 명예교수, 의학사
훔볼트 대학교 의학사박물관의 자우어브르흐 특별전시
지난 해 9월 두 번째로 베를린을 찾았다. 장벽이 무너지기 바로 전 해에 처음 갔으니 31년 만이다. 40시간도 되지 않는 짧은 일정이어서 주로 분단, 통일과 관련된 장소를 찾을 계획이었지만 전공 공부와 관계있는 훔볼트 대학교 의학사박물관을 빠트릴 수는 없었다.
박물관에는 상설전시 외에 자우어브르흐 특별전시가 열리고 있었다. 자우어브르흐(Ferdinand Sauerbruch, 1875?1951는 라이프치히 의과대학 졸업 2년 뒤인 1904년 흉부외과 수술의 전기를 마련한 저압 장치(흔히 자우어브르흐 챔버라고 부름를 만들었고, 스위스 취리히 대학교 교수로 재직하던 제1차 세계대전 시에는 군의관으로 종군하며 당시로는 가장 효과적인 인공팔다리를 개발했으며, 1931년에는 사상 처음 개심술로 심실 동맥류를 제거하는 데 성공했다. 가히 ‘외과의 아이콘’이자 ‘수술의 팔방미인’으로 불릴 인물이다. 자우어브르흐는 뮌헨 대학교를 거쳐 1927년부터 1949년까지 베를린 훔볼트 대학교 외과 교수로 다양한 업적을 남겼을 뿐만 아니라 사회적, 정치적, 인종적 경계를 뛰어넘어 모든 환자에게 헌신적으로 대한 점으로도 사람들의 존경을 받았다. 제2차 세계대전 말 베를린이 연합군의 공중폭격을 받을 때에도 다른 곳으로 피난하지 않고 병원 지하방공호(자우어브르흐 벙커에서 침식을 하며 많은 환자의 목숨을 건지고 그들의 든든한 버팀목이 되었다. 이처럼 자우어브르흐는 외과의 아이콘을 넘어 가장 이상적인 의사의 모습을 보여준 인물이다.
전시는 여기까지가 아니었다. 전시의 후반부는 상세한 자료들로 자우어브르의 또 다른 측면을 낱낱이 드러내고 있었다. 자우어브르흐는 나치당에 가입하지는 않았지만, 1937년 새로 설립된 제국연구심의회의 회원이 되었다. 심의회는 절멸수용소에 감금된 유태인과 전쟁포로들에 대한 인체실험 등